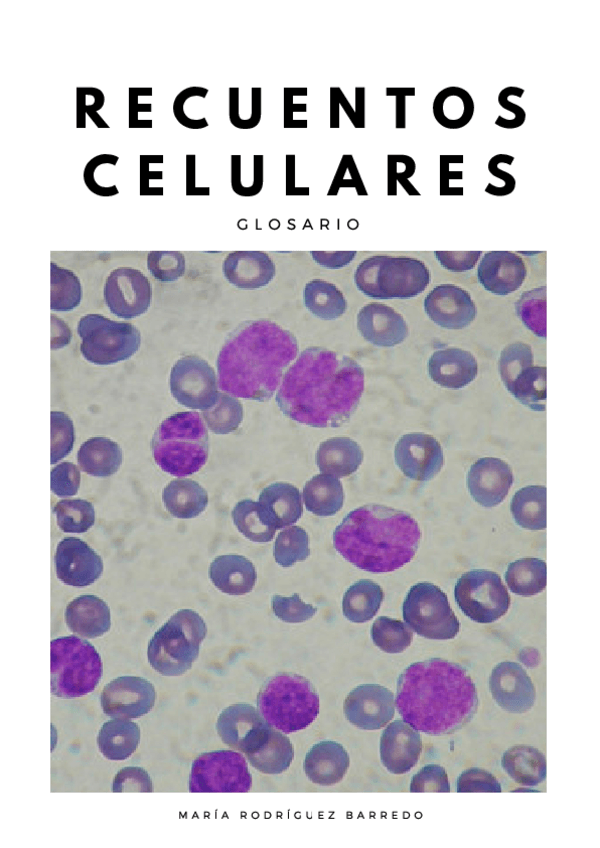

C.F.P.E. Svida Gijón - Laboratorio Clínico y Biomédico
Asturias
Asignaturas de C.F.P.E. Svida Gijón - Laboratorio Clínico y Biomédico
Asignatura
arrow_downwardÚltimas publicaciones de C.F.P.E. Svida Gijón - Laboratorio Clínico y Biomédico
He publicado nuevos trabajos de Técnicas de análisis hematológico: Glosario.pdf
He publicado nuevos trabajos de Gestión de muestras biológicas: Laboratorio-de-Andrologiia-GMB.pdf
He publicado nuevos apuntes de Técnicas generales de laboratorio: Temario-TGL.pdf
He publicado nuevos apuntes de Biología molecular y citogenética: Temario-bmc.pdf
He publicado nuevos trabajos de Empresa e Iniciativa Emprendedora: PLAN-DE-EMPRESA.pdf
He publicado nuevos practicas de Técnicas de inmunodiagnóstico: ilovepdfmerged.pdf
He publicado nuevos trabajos de Microbiología clínica: Streptococcus-pyogenes-2.pdf
He publicado nuevos trabajos de Microbiología clínica: PNT-micropipeta.pdf
He publicado nuevos trabajos de Microbiología clínica: Tincionesmerged.pdf
He publicado nuevos trabajos de Microbiología clínica: Manual-de-Bioseguridad.pdf
He publicado nuevos trabajos de Técnicas de análisis hematológico: Enfermedad-de-chagas.pdf
He publicado nuevos apuntes de Análisis bioquímico: TABLA-RESUMEN-HORMONAS-UNIDAD-3.pdf
He publicado nuevos apuntes de Análisis bioquímico: Glosario-ABmerged.pdf
He publicado nuevos practicas de Gestión de muestras biológicas: Staphylococcus-aereus.pdf
He publicado nuevos trabajos de Formación y orientación laboral: Supuesto-practico.pdf
He publicado nuevos ejercicios de Formación y orientación laboral: LA-SUERTE-DORMIDA-FICHA.pdf
He publicado nuevos ejercicios de Formación y orientación laboral: EJERCICIOS-DE-S-SOCIAL-svida-2021.pdf
He publicado nuevos trabajos de Fisiopatología general: Presentacion-FG.pdf
He publicado nuevos trabajos de Fisiopatología general: FRUCTOSA-copia.pdf
He publicado nuevos trabajos de Biología molecular y citogenética: Anomalias-cromosomicas-numericas.pdf
He publicado nuevos practicas de Técnicas generales de laboratorio: cuaderno-de-practicas-III.pdf
He publicado nuevos practicas de Técnicas generales de laboratorio: Cuaderno-de-practicas-II.pdf
He publicado nuevos practicas de Técnicas generales de laboratorio: Cuaderno-de-practicas.pdf
He publicado nuevos practicas de Técnicas de análisis hematológico: Cuaderno-practicas-TAH-I.pdf